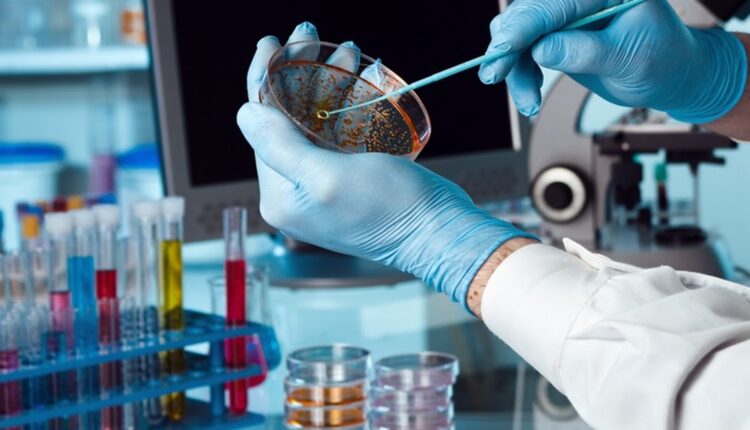

Ιδιαίτερα ανησυχητικά στοιχεία για την εξέλιξη του καρκίνου του ήπατος ανακοίνωσαν ερευνητές, σημειώνοντας πως θα πρέπει να γίνουν αρκετά πράγματα για την καταπολέμηση της νόσου στο μέλλον.
Σύμφωνα με μελέτες, ο αριθμός των ανθρώπων που αναπτύσσουν ή πεθαίνουν από καρκίνο του ήπατος παγκοσμίως θα αυξηθεί πάνω από 55% έως το 2040.
Σχεδόν 905.700 άνθρωποι διαγνώστηκαν με καρκίνο του ήπατος και 830.200 κατέληξαν από την ασθένεια αυτή ανά τον κόσμο το 2020, σύμφωνα με νέα ανάλυση που διενήργησαν επιστήμονες του Διεθνούς Κέντρου Έρευνας για τον καρκίνο (CIRC), το οποίο αποτελεί τμήμα του Παγκόσμιου Οργανισμού Υγείας και έχει την έδρα του στη Λιόν, στη νοτιοανατολική Γαλλία.
Με τον σημερινό ρυθμό, 1,4 εκατομμύριο άνθρωποι θα διαγνωστούν και 1,3 εκατομμύριο θα πεθάνουν από καρκίνο του ήπατος το 2040, σύμφωνα με την ανάλυση.
Αυτό εκτιμάται ότι αντιπροσωπεύει μια αύξηση 500.000 ανθρώπων, τόσο για τον αριθμό των κρουσμάτων όσο και για τον αριθμό των θανάτων, «εκτός εάν επιτυγχάναμε μια σημαντική μείωση των ποσοστών του καρκίνου του ήπατος χάρη στην πρωτογενή πρόληψη», δήλωσε η επιδημιολόγος του CIRC, Χάριετ Ράμγκεϊ, κύρια συντάκτρια της μελέτης που δημοσιεύεται στην Journal of Hepatology (Επιθεώρηση Ηπατολογίας).
Η έρευνα αυτή αποκάλυψε επίσης ότι ο καρκίνος του ήπατος είναι μια από τις κύριες αιτίες θανάτου από καρκίνο σε 46 χώρες – και περιλαμβάνεται στις πέντε πρώτες σε σχεδόν 100 χώρες.
Ο αριθμός των κρουσμάτων και των θανάτων είναι ο υψηλότερος στην ανατολική και τη νοτιοανατολική Ασία καθώς και στη βόρεια Αφρική.
«Ο συγκεκριμένος καρκίνος μπορεί να αποφευχθεί σε μεγάλο βαθμό αν καταβληθούν προσπάθειες ελέγχου — οι κύριοι παράγοντες κινδύνου είναι ο ιός της ηπατίτιδας Β, ο ιός της ηπατίτιδας Γ, η κατανάλωση αλκοόλ, το υπερβολικό βάρος και οι συνθήκες μεταβολισμού, συμπεριλαμβανομένου του διαβήτη τύπου 2», δήλωσε σε ανακοίνωση η συν-συντάκτρια της μελέτης Ιζαμπέλ Σοργιοματαράμ.
Η ζοφερή πρόβλεψη της μελέτης δείχνει την ανάγκη να ενισχυθεί η πρόοδος για την καταπολέμηση των ηπατιτίδων B και Γ, η οποία σταμάτησε λόγω της πανδημίας Covid-19, δήλωσαν οι ερευνητές, ζητώντας περισσότερους εμβολιασμούς, εξετάσεις και θεραπεία.
Η Ράμγκεϊ τάχθηκε επίσης υπέρ της λήψης «μέτρων με στόχο τη μείωση της κατανάλωσης αλκοόλ από τον πληθυσμό και τον δραστικό περιορισμό της αύξησης της συχνότητας του διαβήτη και της παχυσαρκίας».